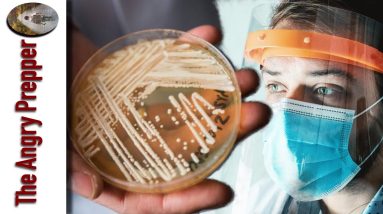
Beware Of This New Problem...

Watch Out for This Latest Issue on the Horizon…
Watch Out for This Latest Issue on the Horizon… Introduction Hey there! Today we’re diving into a pressing issue that’s been making some waves recently. Buckle up and get ready to learn about a fungus that’s been causing quite a…
